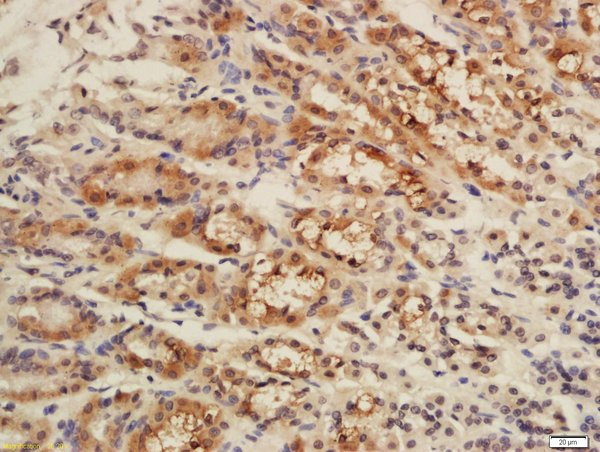
CISD1 Antibody in Immunohistochemistry (Paraffin) (IHC (P))

Search
Bioss
CISD1 Polyclonal Antibody
{{$productOrderCtrl.translations['antibody.pdp.commerceCard.promotion.promotions']}}
{{$productOrderCtrl.translations['antibody.pdp.commerceCard.promotion.viewpromo']}}
{{$productOrderCtrl.translations['antibody.pdp.commerceCard.promotion.promocode']}}: {{promo.promoCode}} {{promo.promoTitle}} {{promo.promoDescription}}. {{$productOrderCtrl.translations['antibody.pdp.commerceCard.promotion.learnmore']}}
产品信息
BS-13959R
种属反应
宿主/亚型
分类
类型
抗原
偶联物
形式
浓度
规格
纯化类型
保存液
内含物
保存条件
运输条件
靶标信息
This gene encodes a protein with a CDGSH iron-sulfur domain and has been shown to bind a redox-active [2Fe-2S] cluster. The encoded protein has been localized to the outer membrane of mitochondria and is thought to play a role in regulation of oxidation. Genes encoding similar proteins are located on chromosomes 4 and 17, and a pseudogene of this gene is located on chromosome 2.
仅用于科研。不用于诊断过程。未经明确授权不得转售。
篇参考文献 (0)
生物信息学
蛋白别名: CDGSH iron sulfur domain-containing protein 1; CDGSH iron-sulfur domain-containing protein 1; Cysteine transaminase CISD1; MGC14684; MitoNEET; unnamed protein product; ZCD1; zinc finger CDGSH-type domain 1; zinc finger, CDGSH-type domain 1
基因别名: AU043990; AW743335; C10orf70; CISD1; D10Ertd214e; MDS029; MitoNEET; RGD1309529; ZCD1
UniProt ID: (Human) Q9NZ45, (Mouse) Q91WS0, (Rat) B0K020
Entrez Gene ID: (Human) 55847, (Mouse) 52637, (Rat) 294362